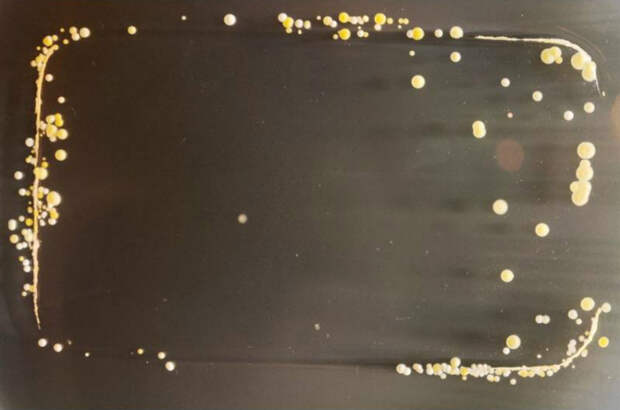

К сожалению, мало кто хоть на минутку задумывается о том, сколько бактерий живет на корпусе любимого гаджета. А ведь многие из них — болезнетворные!

В наши дни сложно представить жизнь без мобильных устройств. Они стали нашими надежными помощниками в поддержании связи с окружающим миром, планировании задач, самовыражении, развлечении…
Почему экран телефона нужно чистить
Эксперимент, проведенный в английском Университете Суррея, подтвердил необходимость регулярной очистки корпуса и экрана мобильного телефона.
Доктор Саймон Пак из вышеуказанного университета предложил своим студентам сделать оттиск их электронных устройств на питательной для бактерий среде в чашах Петри.

Спустя 3 дня исследователи увидели живописные колонии бактерий, населяющих корпус гаджетов.
Доктор Пак говорит, что сильно пугаться не стоит, так как большинство микроорганизмов, населяющих мобильный, безвредны.

Тем не менее, опасные для здоровья также присутствуют, золотистый стафилококк, к примеру, облюбовал многие устройства. Этот вид бактерий является причиной кожных заболеваний, менингита, пневмонии, остеомиелита…

Ученый заключил: «Результаты исследования показали, что мобильники не только запоминают телефонные номера, но и хранят на себе историю наших физических контактов с различными людьми и материалами». На кнопочных устройствах бактерии живут на клавиатуре, а вот уязвимое место сенсорных телефонов — экран.

Лучший выход уберечься от бактерий — регулярное очищение корпуса и экрана телефона при помощи специально предназначенных для этого средств.
Понравилась статья? Поделись ею с другими!
Свежие комментарии